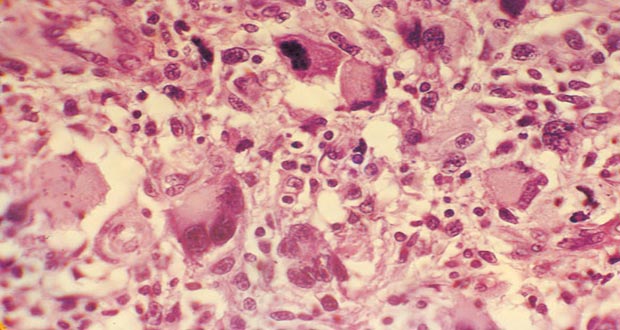

اللاذقية -سانا
يولد آلاف الأطفال حول العالم مصابين بما يسمى الورم المسخي ورغم تصنيفه في قائمة الحالات النادرة يحذر الأطباء من أن إهماله وتأخر كشفه قد يحوله إلى ورم سرطاني.
والورم المسخي حسب اختصاصي جراحة البطن والجراحة التنظيرية الدكتور فادي نوح نوع من الأورام يحتوي على أنواع مختلفة من الأنسجة تكون ناضجة أحيانا كالأسنان والعظام والشعر والجلد وهو سبب تسميته بالمسخي أو العجائبي كما يطلق عليه البعض.
ويوضح الدكتور نوح أن الورم المسخي ورم حميد في أغلب الحالات لكنه قد يتحول إلى خبيث في حال إهمال علاجه لأنه يتراوح بين حميد ناضج وخبيث غير ناضج مشيرا إلى أنه قد يكتشف قبل ولادة الطفل أي في الحياة الجنينية أو بعد الولادة وقد يتأخر إلى سنوات طويلة وذلك وفقا لمكان توضعه وحجمه.
وتختلف الأورام المسخية حسب الاختصاصي في مدى تمايزها ونضج الأنسجة التي تحويها حيث يصل بعضها إلى مرحلة من النضج ليحتوي أصابع وأسنان وعظام وغضاريف بينما يقتصر بعضها الآخر على خليط من الأنسجة غير المتمايزة وفي الحالتين يضم الورم عناصر مختلفة من الأنسجة المستمدة من الطبقات الجنينية الثلاث الداخلية والوسطى والخارجية.
ويذكر الدكتور نوح أن أكثر مناطق انتشار الورم بالجسم هي الناحية العجزية العصعصية والمبيض والخصية والمنطقة المنصفية وخلف الغشاء البريتواني للمعدة وفي العنق وداخل الجمجمة.
وغالبا ما يكتشف الورم المسخي في الناحية العجزية العصعصية قبل الولادة أي في الحياة الجنينية كما يذكر الدكتور نوح إلا أن تأثيره سيئ حيث يسبب زيادة في حجم السائل الأمينوسي واستسقاء جنيني شديد ونزف ضمن كتلة الورم وفقر دم وبالتالي تكون معه نسبة الوفاة كبيرة خلال المرحلة الجنينية تصل حتى 90 بالمئة وفي حال اكتشف بعد الولادة فيترك عيوب خلقية ترتبط بتأثير كتلة الورم ومضاعفات جراحته.
أما بالنسبة للورم في المنطقة المنصفية فيبين الدكتور نوح أنه غالبا ما يكون ورما حميدا ولا يلاحظ له انتشار خارج المنطقة المنصفية ويعد الاستئصال الجراحي كافيا له رغم وجود خطورة للعمل الجراحي نظرا لكثرة المجاورات التشريحية للورم في هذه المنطقة.
والورم المسخي في المبيض من أكثر أورام المبيض انتشارا في سن ما دون العشرين وبنسبة تصل من 10 إلى 20 بالمئة حسب الاختصاصي الذي يشير إلى أن معظمها حميدة إلا أنها تتسبب بمضاعفات كثيرة منها التمزق والنزف والالتواء وفقر الدم نتيجة تحلل الكريات الحمر.
ويضيف الدكتور نوح أن معظم الأورام المسخية في الخصية عند الأطفال حميدة فيما تحدث المضاعفات بعد استئصال الورم كحدوث نزيف أو عدوى مبينا أنه في حال اكتشف الورم بالخصية خلال فترة البلوغ وبعدها يعتبر ورما خبيثا حتما حيث ينتشر بالغدد اللمفاوية في أجهزة الأخرى وقد يكون غير قابل للاستئصال ونسبة عودة الورم فى حالات أورام الخصية المسخية تصل لنحو 20 بالمئة.
ويشخص الورم المسخي كما يوضح الاختصاصي من خلال الأعراض السريرية والتحاليل المخبرية والصورة الشعاعية البسيطة والعلاج بالاستئصال الجراحي للورم الذي يتطلب دقة ومهارة عالية نظرا لقرب الورم من أعضاء مهمة.
ويشير إلى أن الورم قد يكون قابلا للنكس خصوصا عندما يترك جزء منه حفاظا على حيوية أعضاء مهمة مجاورة ملاصقة له مبينا ضرورة متابعة العلاج الجراحي بالعلاج الشعاعي أو الكيماوي اذا أثبت التشريح المرضي وجود الخباثة.
يذكر أن الدكتور نوح نجح مؤخرا في استئصال ورم عجائبي من بطن سيدة بوزن 25 كغ واستغرق العمل الجراحي منذ بدأ التخدير وحتى صحو المريضة أربع ساعات وبلغ وزن ما استأصل من جلد إضافة إلى الكتلة 37 كغ.
لين علي
S A N A الوكالة العربية السورية للأنباء